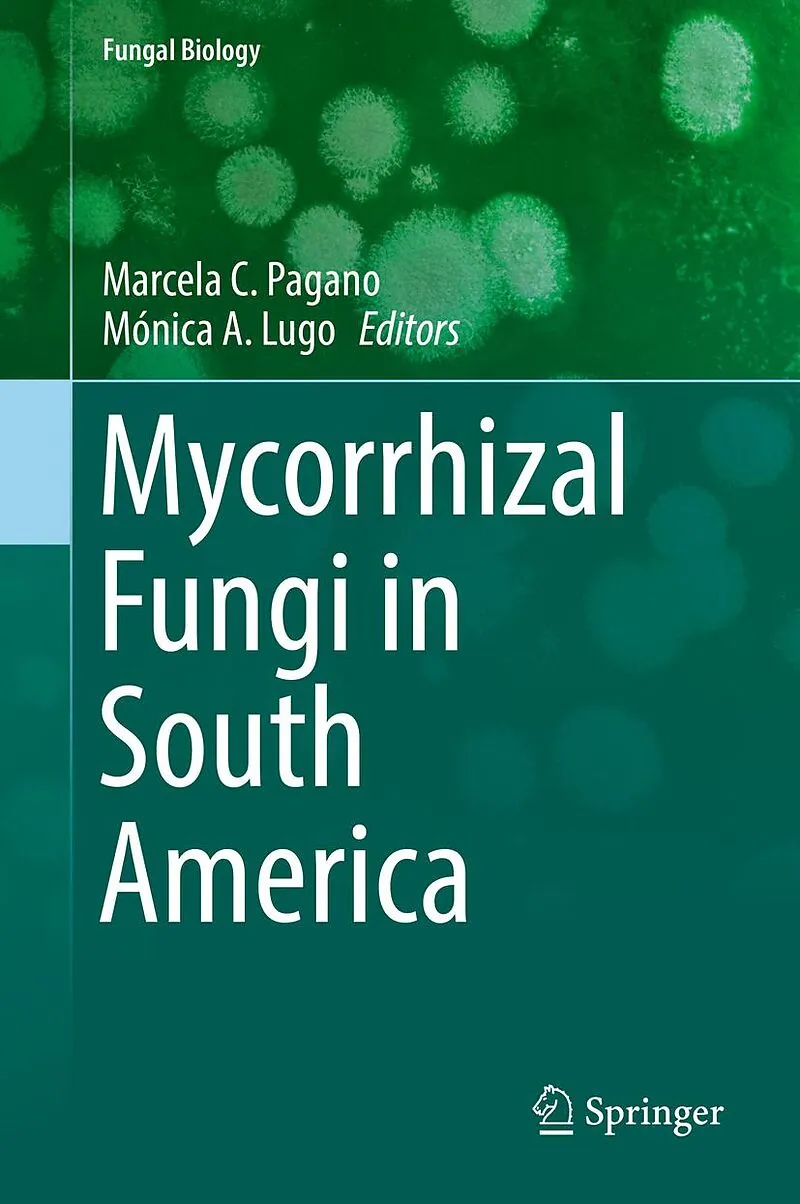

Beschreibung
This new book shows the work done by researchers dedicated to the study of different mycorrhizas types, the fungal species associated and their distribution influenced by geographical and environmental factors among the different South American biogeographic ...This new book shows the work done by researchers dedicated to the study of different mycorrhizas types, the fungal species associated and their distribution influenced by geographical and environmental factors among the different South American biogeographic regions. The exclusive biotic and abiotic characteristics delimit natural ecosystems with uniques biological communities, where mycorrhizologists have investigated plant symbioses in those ecosystems for decades, providing data from Venezuelan Great Savannah, Andes, Puna, Chaco, Caatinga, Monte, Atlantic Forest, Marginal Forest, Cerrado, Patagonia, Yungas, Rainforest, Andean-Patagonian Forests, and Antarctic section. In these environments, different mycorrhizal associations (arbuscular / ericoid / orchidoid / ectomycorrhizal / mycoheterotrophic) are present in herbaceous plants, shrubs, and trees. Mycorrhizal associations were studied from different researching points of view (biodiversity, biological invasions, biotic / abiotic disturbances, altitudinal variations, seasonal changes, land uses). The aim of this Book is to compile research on mycorrhizal fungi and their associations in environments of South America, throughout the synthesis of information from natural and anthropogenic related environments. The book focuses in different bioregions of South America from tropical areas to the southern cone, and it will be useful to those who work on plant-fungal interactions in different vegetation types and in agricultural lands from South America and worldwide.
Autorentext
Dr. Marcela Claudia PaganoMarcela Pagano was born in La Plata, Argentina. She taught for some years at high school and Universities. In 2018 she was appointed as Technical analyst in Health Promotion and Management at Sanitary Surveillance Board, Santa Catarina, Brazil. Prior to that, she spent over 10 years in mycorrhizal research, completing her PhD at the Federal University of Minas Gerais, Brazil and four postdoctoral fellowships.Education: Dr. Pagano completed her D.Sc. (Sciences - Applied Botany) and her MSc in Ecology, Conservation and Wild Life Management from Federal University of Minas Gerais, Brazil.Experience: She has vast experience in different areas of plant-soil-fungal biology, to name a few: Rhizobial and mycorrhizal symbiosis, Nanomaterials focusing on anthropogenic soils and biochar, terrestrial ecology, etc.Publication: Since 1998, 28 papers published in national and international peer reviewed journals like Ecological Indicators, Applied Soil Ecology, Symbiosis, Soil & Tillage Research, etc. and from different journals of Elsevier, Springer, etc.International collaboration: Dr. Pagano also collaborate in research projects in Brazil and with other research groups, which has resulted in 27 book chapters and 2 edited books.Editorial Experience: She is editorial board member of three International Journals (European Journal of Soil Biology, Frontiers in Microbiology).Specialization Keywords: Plant-soil interactions /soil ecology, mycorrhizal fungi, plant symbiosis, Nanomaterials
**Prof. Dr. Mónica Alejandra Lugo **MICODIF- IMIBIO-CONICET-UNSL- Facultad de Química, Bioquímica y Farmacia, 5700, San Luis, Argentina. e-mail lugo@unsl.edu.ar/monicalugo63@gmail.comML was born in Tigre, Argentina. She taught for 28 years at high school and Universities such as National University of Buenos Aires, National University of Córdoba and National University of San Luis; and her current positions are Adjunct professor (Biology Department, FQByF, National University of San Luis) to Bachelor of Biological Sciences and to Professor in Biological Sciences, becoming Professor of Vegetal Diversity I, Plant-Fungi interactions: Mycophyllas and Mycorrhizas, Biology of Protist and Fungi and Fungi and Vegetal Systematic. She won three Doctoral Scholarships (1994-1999) and a Postdoc Fellowship (1999-2001). Further, she is the Director of the Mycology, Diversity and Fungi interaction Herbarium (MICODIF) of the National University of San Luis-SNDB (National System of Biological Data-Argentina).Education: Dr. Lugo completed her D.Sc. (Biological Sciences) from National University of Córdoba, Argentina.Experience: She has worked in diverse research topics such as: Plan-Fungi associations (stem fungal endophytes/mycophyllas, arbuscular mycorrhizas and dark septate endophytes, ectomycorrhizas ecology), Environmental Microbiology (plants and soil microorganisms interactions in highlands, stressed, arid and semi-arid native and agronomic ecosystems, secondary communities), Mycology, fungal diversity, etc.Publication: Since 1995, 24 papers published in national and international peer reviewed journals like Microbial Ecology, Mycologia, Symbiosis, Mycorrhiza, Pedobiologia, Journal of Arid Environments, etc., published also 3 Book Chapters, 1 Book of Research Methodologies, 2 Didactic Books from different editorial such as NOVA Science Publishers, Springer, etc.International collaboration: Dr. Lugo also collaborate in research projects in Argentina, Colombia, Italy and with other research groups.Editorial Experience: She has reviewed research works as expert reviewer of International Journals (Applied Soil Ecology, Fungal Ecology, Microbial Ecology, Mycorrhiza, Symbiosis, etc.) and National Journals.Specialization Keywords: Plant-soil interactions /soil ecology, mycorrhizal fungi, plant symbiosis/arid, semiarid, highlands, stressed environments
Inhalt
1 Overview of the Mycorrhizal Fungi in South America. Lugo, M; Pagano, M.
2 Mycorrhizal types in native and exotic woody species in Southern South America: a biogeographic approach. Urcelay Carlos, Tecco Paula, et al.
3 Arbuscular Mycorrhizal Fungi in South America. Cofré N., Soteras F., S. Velázquez, Camila Abarca, Risio, Ontivero, Lugo
4 Ectomycorrhizal Southeamerican Fungi: their diversity in the past, present and future. Nouhra, Götz Palfner, Francisco Kuhar, Geml, Andrew Smith
5 North vs. South Hemisphere: Mycorrhizas information and southern integration. Marín C., Bueno, et al.
6 Northern Tropical South America. Pena Venegas Clara
7 Tropical and Subtropical rain forest, Grand Chaco region: Orchidiod mycorrhizas in South America. Otero, Yasmin Alomia, et al.
8 Great Savannah. Lovera, Cuenca, et al.
9 Tropical Dry Forest compared to Rainforest. Pagano, Zangaro, de Souza F, Costa Maia L. et al.
10 Yunga. Becerra, Nouhra , Geml
11 Caatinga, Cerrado and Central Sabanas. Moura Jadson, Juliana Silva Rodrigues Cabral et al.
12 Chaco region: arid and semiarid forest, shrublands and mountain grasslands. Grilli, Risio, et al.
13 Arid Southern Highlands: Puna and Altiplano. Lugo, Menoyo, Urcelay et al.
14 Tabaquillo (Polylepis australis Bitter) Mountain Forest. Soteras, Menoyo, Becerra
15 Dry forest and open woodlands: Chilean matorral. Silva-Flores, Ana Aguilar
16 Salares and Deserts. Cofré, Soteras, Becerra, et al.
17 South American temperate region: Valdivian and Patagonian forests. Godoy, Marín (César), Fontela, Natalia Fernández, etc.
18 South American anthropic environments. Pagano, Risio, , Ontivero, Cofré, Covacevich, Erica Lumini et al.
19 Arbuscular mycorrhizal fungi in volcanic soils. Paula Aguilera, Fernando Borie y Pablo Cornejo.
20 Patagonian steppe. Fontela, Javier Puntieri, et al.
21 The native broadleaf and conifer Andean-patagonic forest: anthropic intervention. M. Eugenia Salomón, C. Barroetaveña, Mario Rajchenberg,
22 Belowground Invasions in South America. Núñez Martín, Nahuel Policelli, et al.
